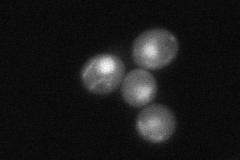
YOL096C

View description
O-methyltransferase, catalyzes two different O-methylation steps in ubiquinone (Coenzyme Q) biosynthesis; component of a mitochondrial ubiquinone-synthesizing complex; phosphoprotein
Localization:
Intensity:
Fold change:
Significance:
-
C’ GFP library in SD

mitochondria20.32 -
N' NOP1pr-GFP in SD

mitochondria87.1631 -
N' TEF2pr-mCherry in SD

punctate,mitochondria32.1973 -
N' NATIVEpr-GFP in SD
below threshold25.065 -
N' TEF2pr-VC and Cyto-VN in SD

#N/A0 -
C’ GFP library in SD+DTT

mitochondria24.011.18No -
C’ GFP library in SD+H2O2

mitochondria19.480.95No -
C’ GFP library in Starvation Media

mitochondria35.111.72No -
C’ GFP library on the background of Pup2-DaMP

mitochondria -
C’ GFP library on the background of CCT mutant

mitochondria17.11340.84214No
